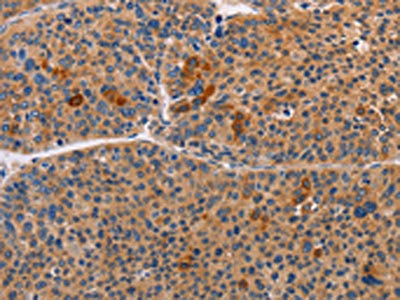

ALDH3A1 Antibody
-
中文名稱:ALDH3A1兔多克隆抗體
-
貨號:CSB-PA272721
-
規(guī)格:¥1100
-
圖片:
-
The image on the left is immunohistochemistry of paraffin-embedded Human gastic cancer tissue using CSB-PA272721(ALDH3A1 Antibody) at dilution 1/55, on the right is treated with fusion protein. (Original magnification: ×200)
-
The image on the left is immunohistochemistry of paraffin-embedded Human liver cancer tissue using CSB-PA272721(ALDH3A1 Antibody) at dilution 1/55, on the right is treated with fusion protein. (Original magnification: ×200)
-
Gel: 10%SDS-PAGE, Lysate: 40 μg, Lane 1-2: A549 cells, mouse eye tissue, Primary antibody: CSB-PA272721(ALDH3A1 Antibody) at dilution 1/750, Secondary antibody: Goat anti rabbit IgG at 1/8000 dilution, Exposure time: 10 seconds
-
-
其他:
產(chǎn)品詳情
-
Uniprot No.:
-
基因名:ALDH3A1
-
別名:Acetaldehyde dehydrogenase 3 antibody; AHD 4 antibody; AHD C antibody; AHD4 antibody; AHDC antibody; AL3A1_HUMAN antibody; Aldehyde dehydrogenase 3 antibody; Aldehyde dehydrogenase 3 family member A1 antibody; Aldehyde dehydrogenase 3A1 antibody; Aldehyde dehydrogenase antibody; Aldehyde dehydrogenase class 3 antibody; Aldehyde dehydrogenase dimeric NADP preferring antibody; Aldehyde dehydrogenase family 3 member A1 antibody; Aldehyde dehydrogenase family 3 subfamily A1 antibody; Aldehyde dehydrogenase family 3, subfamily A, member 1 antibody; Aldehyde dehydrogenase isozyme 3 antibody; Aldehyde dehydrogenase type III antibody; ALDH 3 antibody; ALDH 3A1 antibody; ALDH III antibody; ALDH, stomach type antibody; ALDH3 A1 antibody; ALDH3 antibody; ALDH3A 1 antibody; Aldh3a1 antibody; ALDHIII antibody; dimeric NADP-preferring antibody; MGC10406 antibody; Stomach aldehyde dehydrogenase antibody; Tumor associated aldehyde dehydrogenase tumor ALDH antibody
-
宿主:Rabbit
-
反應(yīng)種屬:Human,Mouse,Rat
-
免疫原:Fusion protein of Human ALDH3A1
-
免疫原種屬:Homo sapiens (Human)
-
標(biāo)記方式:Non-conjugated
-
抗體亞型:IgG
-
純化方式:Antigen affinity purification
-
濃度:It differs from different batches. Please contact us to confirm it.
-
保存緩沖液:-20°C, pH7.4 PBS, 0.05% NaN3, 40% Glycerol
-
產(chǎn)品提供形式:Liquid
-
應(yīng)用范圍:ELISA,WB,IHC
-
推薦稀釋比:
Application Recommended Dilution ELISA 1:2000-1:5000 WB 1:500-1:2000 IHC 1:50-1:200 -
Protocols:
-
儲存條件:Upon receipt, store at -20°C or -80°C. Avoid repeated freeze.
-
貨期:Basically, we can dispatch the products out in 1-3 working days after receiving your orders. Delivery time maybe differs from different purchasing way or location, please kindly consult your local distributors for specific delivery time.
-
用途:For Research Use Only. Not for use in diagnostic or therapeutic procedures.
相關(guān)產(chǎn)品
靶點(diǎn)詳情
-
功能:ALDHs play a major role in the detoxification of alcohol-derived acetaldehyde (Probable). They are involved in the metabolism of corticosteroids, biogenic amines, neurotransmitters, and lipid peroxidation (Probable). Oxidizes medium and long chain aldehydes into non-toxic fatty acids. Preferentially oxidizes aromatic aldehyde substrates. Comprises about 50 percent of corneal epithelial soluble proteins. May play a role in preventing corneal damage caused by ultraviolet light.
-
基因功能參考文獻(xiàn):
- ALDH3A1 appears to play an essential role in protecting cellular proteins against aggregation under stress conditions PMID: 28526614
- ALDH3A1 confers a multi-modality resistance phenotype in MCF-7 cells PMID: 27276244
- Molecular docking analysis depicted that Sulforaphane fits into the active site of ALDH3A1, and facilitates the catalytic mechanism of the enzyme. PMID: 27997560
- ALDH-3A1 expression correlates well with gastric cancer dysplasia and grades, differentiation, lymph node metastasis and cancer stage. PMID: 27279633
- Down-regulation of ALDH3 activity in trophoblast stem cells initiates trophoblast differentiation during placental development. PMID: 26124079
- ALDH3A1 has a role in the maintenance of corneal epithelial homeostasis by simultaneously modulating proliferation and differentiation through both enzymatic and non-enzymatic mechanisms PMID: 26751691
- Reported increased expression of ALDH3A1, PDIA3, and PRDX2 in pterygia using a proteomic approach. These proteins are presumed to have a protective role against oxidative stress-induced apoptosis. PMID: 25221425
- SiRNA-mediated suppression of ALDH3A1 blocked ALDH enzymatic activity and augmented cytotoxicity in CSE-exposed cells. PMID: 24316006
- While ALDH3A1 was not found in prostate glands, it was present in prostatic intraepithelial neoplasia, further increased in carcinomas, and upregulated in lymphatic metastases. ALDH3A1 increased in DU145-cell-derived lung metastasis vs. local xenografts. PMID: 24762960
- No correlation between ALDH3A1 expression and patient survival or tumour recurrence was observed.In conclusion, ALDH3A1 is a marker of activation of the Wnt/ss-catenin pathway in hepatocellular carcinoma PMID: 24276407
- ALDH3A1 provides exceptional protection from the adverse effects of pathophysiological concentrations of 4-HNE such as may occur during periods of oxidative stress PMID: 22406320
- through modulation of PPARgamma or ALDH3A1, it may be possible to reduce cell proliferation in tumor cells or stimulate cell proliferation in normal cells during tissue regeneration. PMID: 21251908
- the UV-induced inactivation of ALDH3A1 is a result of non-native aggregation and associated structural changes rather than specific damage to the active site Cys PMID: 21203538
- Antihypertensives, nonopioid analgesics and hormonal contraceptives significantly affect the salivary ALDH3A1 activity. PMID: 21229876
- These findings suggest that a high level of expression of ALDH3 in cancerous liver tissues resulted from the expression or activation of at least two nuclear proteins reacting to the ALDH3 promoter region. PMID: 9855707
- ADH3*1 allele associated with high ADH activity and acetyaldehyde-DNA adducts in lung; may be a risk factor for lung cancer PMID: 12367788
- ALDH3A1 is a regulatory element of the cellular defense system that protects corneal epithelium against UV-induced oxidative damage PMID: 12706498
- Enzyme activity and localization of ALDH3A1 in the cornea. PMID: 12943535
- ALDH3A1 may protect corneal epithelial cells against oxidative damage not only through its metabolic function but also by prolonging the cell cycle PMID: 15905174
- In most cases, ALDH3A1 activity in tumor and bordering tissues was higher than in a control group PMID: 18536178
- the mechanism of salivary ALDH3A1 inactivation must be related to free radical activity, presumably in the salivary gland, but it is not simply correlated with antioxidatn capacity of saliva PMID: 19894643
顯示更多
收起更多
-
亞細(xì)胞定位:Cytoplasm.
-
蛋白家族:Aldehyde dehydrogenase family
-
組織特異性:High levels in stomach, esophagus and lung; low level in the liver and kidney.
-
數(shù)據(jù)庫鏈接:
Most popular with customers
-
-
YWHAB Recombinant Monoclonal Antibody
Applications: ELISA, WB, IHC, IF, FC
Species Reactivity: Human, Mouse, Rat
-
Phospho-YAP1 (S127) Recombinant Monoclonal Antibody
Applications: ELISA, WB, IHC
Species Reactivity: Human
-
-
-
-
-